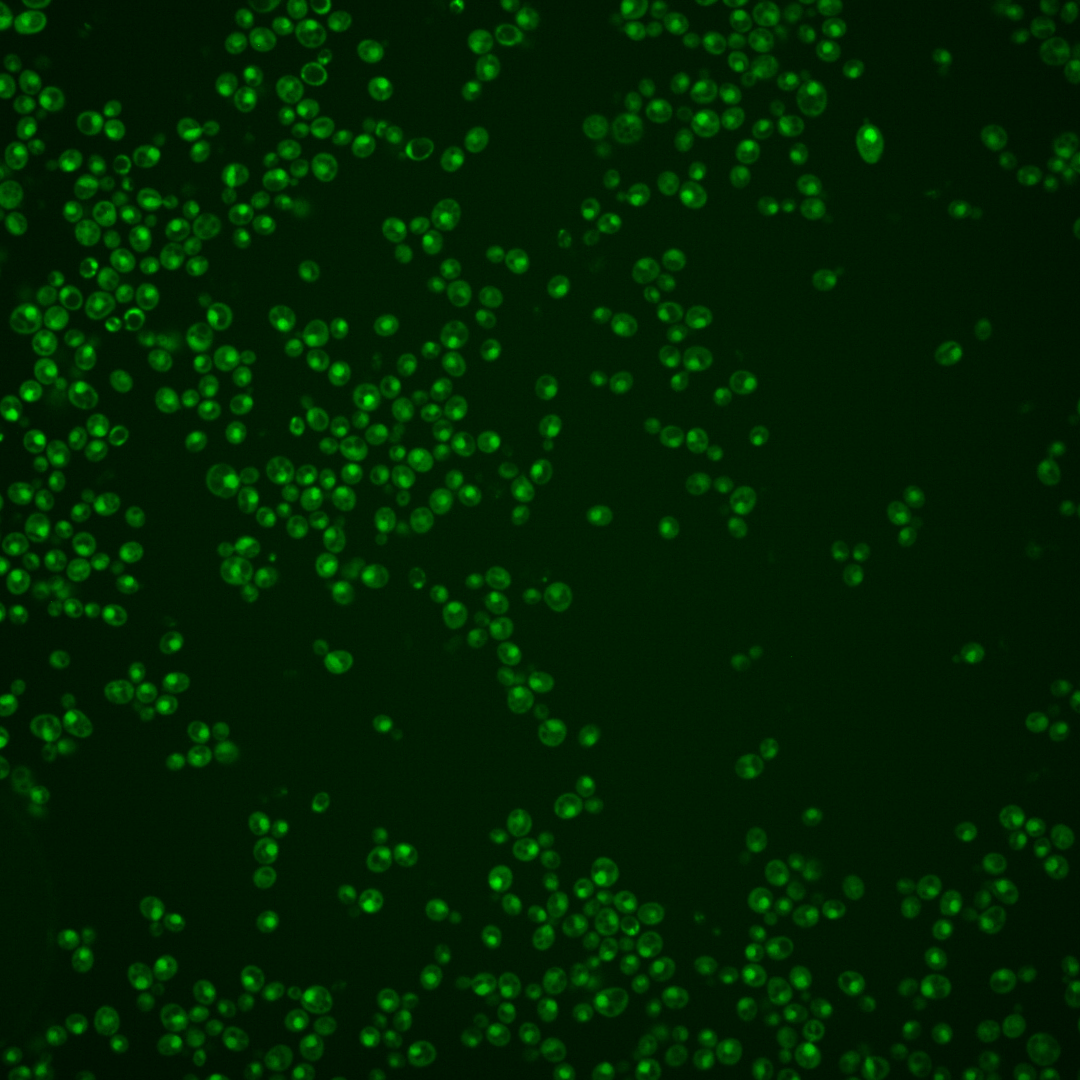
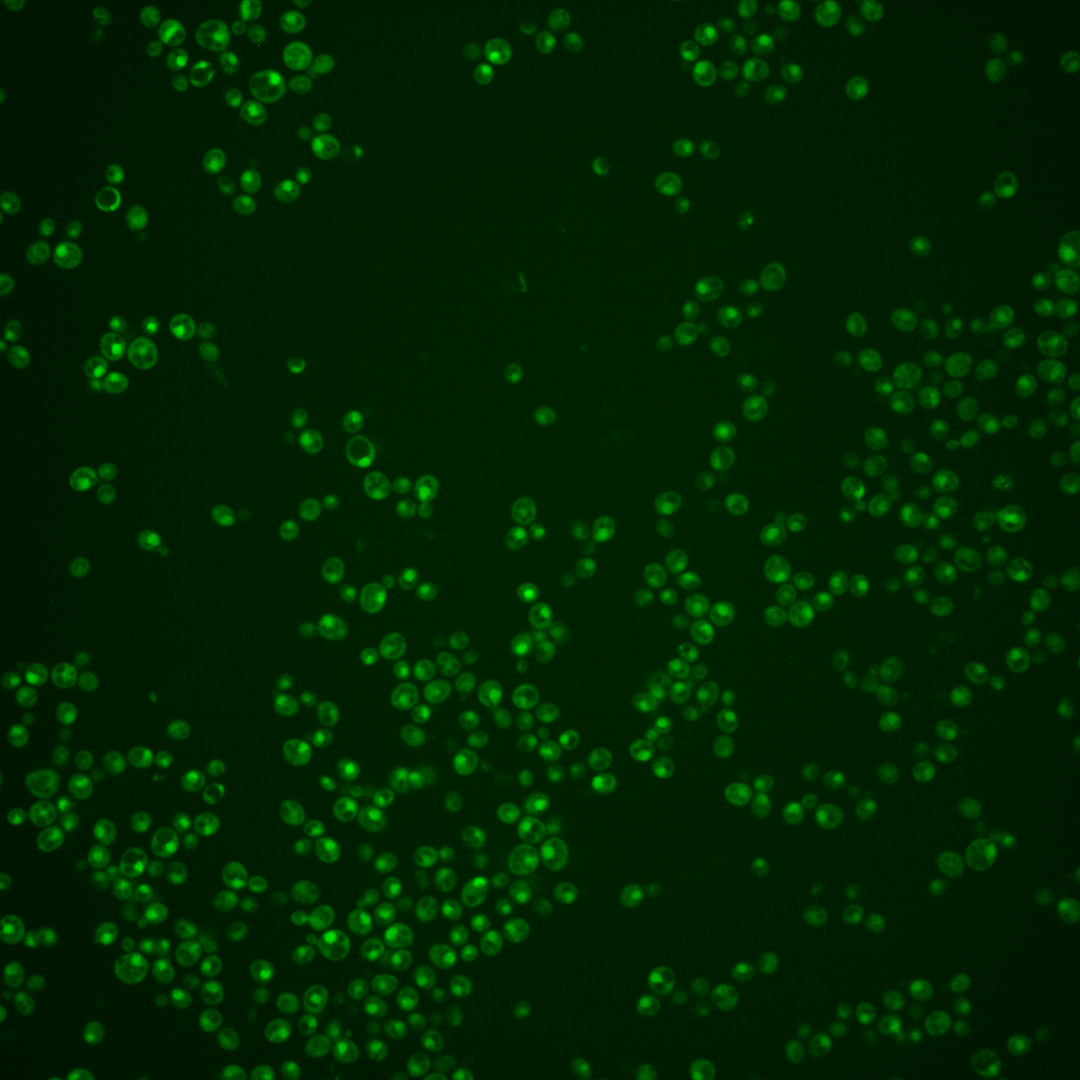
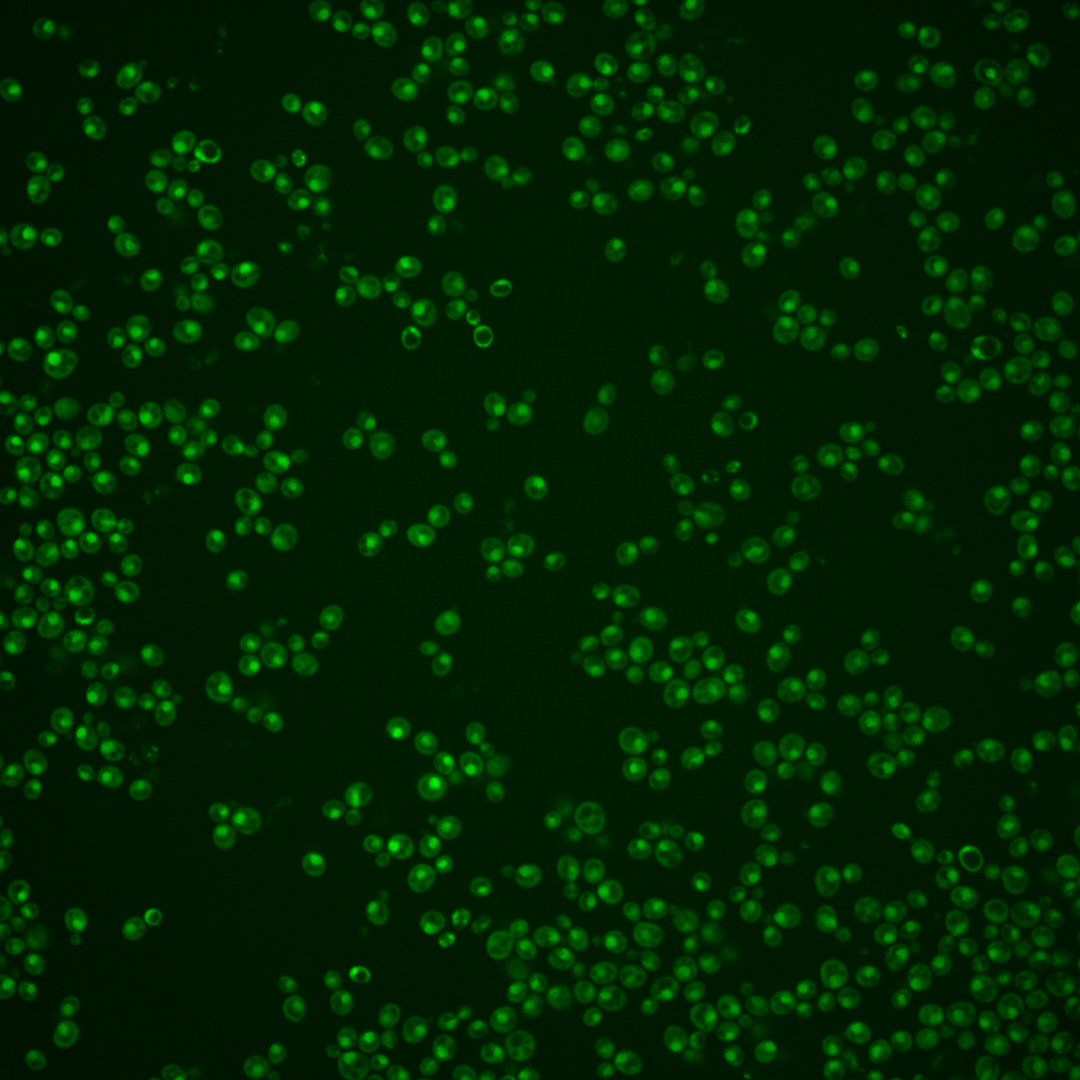

| Standard name | |
|---|---|
| Human Ortholog | |
| Description | Scaffold protein; assists in association of the proteasome core particle with the regulatory particle; inhibits proteasomal ATPase activity; degraded by the mature proteasome after assembly; contains HEAT-like repeats; protein increases in abundance and relocalizes from nucleus to cytoplasm upon DNA replication stress |
Micrographs




















































































Sub-cellular Localization
Yeast GFP Assignment
Protein Abundance
Localization Change
External localization resources
| ensLOC | DeepLoc | |||||||||||||||||||||||
|---|---|---|---|---|---|---|---|---|---|---|---|---|---|---|---|---|---|---|---|---|---|---|---|---|
| Localization | WT1 | WT2 | WT3 | RAP60 | RAP140 | RAP220 | RAP300 | RAP380 | RAP460 | RAP540 | RAP620 | RAP700 | HU80 | HU120 | HU160 | rpd3Δ_1 | rpd3Δ_2 | rpd3Δ_3 | WT1 | WT2 | WT3 | AF100 | AF140 | AF180 |
| Cortical Patches | 0 | 1 | 0 | 0 | 0 | 0 | 0 | 0 | 0 | 0 | 1 | 1 | 0 | 0 | 0 | – | 0 | – | 0 | 0 | 1 | 0 | 0 | 0 |
| Bud | 0 | 1 | 3 | 0 | 2 | 1 | 4 | 7 | 3 | 2 | 9 | 16 | 0 | 0 | 0 | – | 0 | – | 4 | 5 | 7 | 11 | 14 | 9 |
| Bud Neck | 0 | 0 | 1 | 0 | 0 | 0 | 0 | 0 | 0 | 0 | 0 | 0 | 0 | 0 | 0 | – | 0 | – | 0 | 0 | 1 | 0 | 2 | 1 |
| Bud Site | 0 | 0 | 0 | 0 | 0 | 1 | 3 | 17 | 6 | 3 | 9 | 12 | 0 | 0 | 0 | – | 0 | – | – | – | – | – | – | – |
| Cell Periphery | 0 | 0 | 0 | 0 | 0 | 0 | 0 | 0 | 0 | 0 | 2 | 0 | 0 | 0 | 0 | – | 0 | – | 0 | 0 | 0 | 0 | 0 | 0 |
| Cytoplasm | 12 | 15 | 24 | 15 | 44 | 30 | 38 | 56 | 25 | 37 | 31 | 59 | 40 | 63 | 56 | – | 7 | – | 11 | 10 | 20 | 5 | 8 | 7 |
| Endoplasmic Reticulum | 0 | 0 | 1 | 1 | 2 | 0 | 0 | 0 | 0 | 0 | 0 | 0 | 0 | 2 | 2 | – | 0 | – | 0 | 0 | 3 | 0 | 1 | 2 |
| Endosome | 5 | 1 | 10 | 1 | 6 | 1 | 5 | 4 | 0 | 1 | 0 | 0 | 1 | 1 | 2 | – | 0 | – | 5 | 5 | 2 | 1 | 6 | 7 |
| Golgi | 0 | 0 | 0 | 0 | 0 | 0 | 0 | 0 | 0 | 0 | 0 | 0 | 0 | 0 | 0 | – | 0 | – | 1 | 0 | 0 | 0 | 1 | 4 |
| Mitochondria | 3 | 4 | 54 | 64 | 22 | 117 | 132 | 234 | 179 | 235 | 218 | 313 | 2 | 0 | 9 | – | 0 | – | 1 | 2 | 7 | 0 | 3 | 2 |
| Nucleus | 248 | 107 | 162 | 100 | 104 | 135 | 196 | 300 | 124 | 152 | 133 | 165 | 97 | 145 | 196 | – | 5 | – | 323 | 171 | 214 | 177 | 229 | 215 |
| Nuclear Periphery | 1 | 0 | 0 | 0 | 1 | 0 | 2 | 1 | 5 | 3 | 1 | 4 | 1 | 1 | 0 | – | 0 | – | 5 | 0 | 3 | 0 | 1 | 2 |
| Nucleolus | 1 | 0 | 0 | 1 | 1 | 0 | 0 | 5 | 0 | 1 | 0 | 1 | 1 | 1 | 2 | – | 0 | – | 12 | 3 | 5 | 4 | 7 | 9 |
| Peroxisomes | 0 | 0 | 0 | 0 | 0 | 0 | 0 | 0 | 0 | 0 | 0 | 0 | 0 | 0 | 0 | – | 0 | – | 0 | 0 | 0 | 0 | 0 | 0 |
| SpindlePole | 0 | 0 | 0 | 0 | 0 | 0 | 0 | 2 | 0 | 0 | 1 | 0 | 0 | 0 | 0 | – | 0 | – | 7 | 4 | 5 | 2 | 4 | 4 |
| Vac/Vac Membrane | 139 | 88 | 63 | 41 | 122 | 82 | 69 | 82 | 47 | 41 | 41 | 77 | 110 | 95 | 66 | – | 9 | – | 44 | 21 | 66 | 26 | 39 | 55 |
| Unique Cell Count | 362 | 192 | 274 | 177 | 270 | 291 | 352 | 519 | 282 | 344 | 314 | 453 | 230 | 294 | 320 | 20 | 420 | 226 | 343 | 233 | 324 | 324 | ||
| Labelled Cell Count | 409 | 217 | 318 | 223 | 304 | 367 | 449 | 708 | 389 | 475 | 446 | 648 | 252 | 308 | 333 | 21 | 420 | 226 | 343 | 233 | 324 | 324 | ||
Yeast GFP Assignment
Protein Abundance
| Screen | WT1 | WT2 | WT3 | RAP60 | RAP140 | RAP220 | RAP300 | RAP380 | RAP460 | RAP540 | RAP620 | RAP700 | HU80 | HU120 | HU160 | rpd3Δ_1 | rpd3Δ_2 | rpd3Δ_3 | AF100 | AF140 | AF180 |
|---|---|---|---|---|---|---|---|---|---|---|---|---|---|---|---|---|---|---|---|---|---|
| Mean Cell GFP Intensity (1e-4) | 8.6 | 6.6 | 5.1 | 4.9 | 5.9 | 5.0 | 4.8 | 4.7 | 4.0 | 3.7 | 3.6 | 3.5 | 7.8 | 8.0 | 6.7 | – | 14.3 | – | 7.6 | 8.1 | 8.9 |
| Std Deviation (1e-4) | 1.2 | 1.3 | 0.9 | 1.0 | 1.3 | 0.8 | 1.1 | 1.3 | 1.1 | 1.0 | 1.0 | 1.1 | 1.6 | 1.7 | 1.5 | – | 3.8 | – | 1.4 | 1.7 | 1.7 |
| Intensity Change (Log2) | – | – | – | -0.06 | 0.2 | -0.04 | -0.11 | -0.14 | -0.37 | -0.46 | -0.52 | -0.54 | 0.61 | 0.64 | 0.37 | – | 1.47 | – | 0.56 | 0.66 | 0.79 |
Localization Change
| Localization | RAP60 | RAP140 | RAP220 | RAP300 | RAP380 | RAP460 | RAP540 | RAP620 | RAP700 | HU80 | HU120 | HU160 | rpd3Δ_1 | rpd3Δ_2 | rpd3Δ_3 |
|---|---|---|---|---|---|---|---|---|---|---|---|---|---|---|---|
| Cortical Patches | 0 | 0 | 0 | 0 | 0 | 0 | 0 | 0 | 0 | 0 | 0 | 0 | – | 0 | – |
| Bud | 0 | 0 | 0 | 0 | 0 | 0 | 0 | 0 | 0 | 0 | 0 | 0 | – | 0 | – |
| Bud Neck | 0 | 0 | 0 | 0 | 0 | 0 | 0 | 0 | 0 | 0 | 0 | 0 | – | 0 | – |
| Bud Site | 0 | 0 | 0 | 0 | 0 | 0 | 0 | 0 | 0 | 0 | 0 | 0 | – | 0 | – |
| Cell Periphery | 0 | 0 | 0 | 0 | 0 | 0 | 0 | 0 | 0 | 0 | 0 | 0 | – | 0 | – |
| Cytoplasm | -0.1 | 2.7 | 0.6 | 0.8 | 0.9 | 0 | 0.8 | 0.5 | 1.8 | 2.9 | 4.2 | 3.1 | – | 0 | – |
| Endoplasmic Reticulum | 0 | 0 | 0 | 0 | 0 | 0 | 0 | 0 | 0 | 0 | 0 | 0 | – | 0 | – |
| Endosome | 0 | -1.0 | -2.8 | 0 | 0 | 0 | 0 | 0 | 0 | -2.5 | -2.9 | -2.6 | – | 0 | – |
| Golgi | 0 | 0 | 0 | 0 | 0 | 0 | 0 | 0 | 0 | 0 | 0 | 0 | – | 0 | – |
| Mitochondria | 3.9 | -3.9 | 5.3 | 0 | 0 | 0 | 0 | 0 | 0 | -6.7 | -8.0 | -6.7 | – | 0 | – |
| Nucleus | -0.6 | -4.8 | -3.0 | -0.9 | -0.4 | -3.6 | -3.7 | -4.1 | -6.0 | -3.8 | -2.3 | 0.5 | – | -3.0 | – |
| Nuclear Periphery | 0 | 0 | 0 | 0 | 0 | 0 | 0 | 0 | 0 | 0 | 0 | 0 | – | 0 | – |
| Nucleolus | 0 | 0 | 0 | 0 | 0 | 0 | 0 | 0 | 0 | 0 | 0 | 0 | – | 0 | – |
| Peroxisomes | 0 | 0 | 0 | 0 | 0 | 0 | 0 | 0 | 0 | 0 | 0 | 0 | – | 0 | – |
| SpindlePole | 0 | 0 | 0 | 0 | 0 | 0 | 0 | 0 | 0 | 0 | 0 | 0 | – | 0 | – |
| Vacuole | 0 | 5.5 | 1.4 | -1.0 | -2.5 | -1.9 | -3.7 | -3.1 | -2.0 | 5.8 | 2.5 | -0.7 | – | 0 | – |
External localization resources
Images






























Protein Concentration and Protein Localization Data
| R1 | R2 | R3 | ||||||||||||||||
|---|---|---|---|---|---|---|---|---|---|---|---|---|---|---|---|---|---|---|
| G1 Pre-START | G1 Post-START | S/G2 | Metaphase | Anaphase | Telophase | G1 Pre-START | G1 Post-START | S/G2 | Metaphase | Anaphase | Telophase | G1 Pre-START | G1 Post-START | S/G2 | Metaphase | Anaphase | Telophase | |
| Concentration | 4.5385 | 5.6897 | 5.1172 | 4.2798 | 3.8645 | 5.4419 | 5.6034 | 7.301 | 6.2964 | 6.6106 | 5.4918 | 6.6648 | 7.2085 | 7.9574 | 6.7637 | 6.8374 | 6.8298 | 6.8561 |
| Actin | 0.0286 | 0.0005 | 0.0106 | 0.003 | 0.0016 | 0.0002 | 0.0489 | 0.0096 | 0.0019 | 0.0048 | 0.0004 | 0.0002 | 0.0152 | 0.0001 | 0.0104 | 0.0031 | 0.0149 | 0.0015 |
| Bud | 0.0006 | 0.0002 | 0.0001 | 0.0002 | 0.0004 | 0.0001 | 0.0008 | 0.0004 | 0 | 0.0003 | 0 | 0.0001 | 0.0009 | 0.0001 | 0.0003 | 0.0003 | 0.0002 | 0.0002 |
| Bud Neck | 0.0013 | 0.0005 | 0.0003 | 0.0015 | 0.0008 | 0.0041 | 0.0036 | 0.0012 | 0.0002 | 0.0007 | 0.0002 | 0.0021 | 0.0023 | 0.0094 | 0.0006 | 0.0017 | 0.001 | 0.0016 |
| Bud Periphery | 0.0011 | 0.0001 | 0.0001 | 0.0002 | 0.0014 | 0.0006 | 0.0016 | 0.0003 | 0 | 0.001 | 0 | 0.0002 | 0.001 | 0.0001 | 0.0002 | 0.0006 | 0.0011 | 0.0003 |
| Bud Site | 0.0026 | 0.0009 | 0.0003 | 0.0006 | 0.001 | 0.0001 | 0.0027 | 0.0078 | 0.0002 | 0.0007 | 0.0001 | 0.0001 | 0.0129 | 0.0058 | 0.0022 | 0.0005 | 0.0006 | 0.0002 |
| Cell Periphery | 0.0003 | 0 | 0 | 0.0001 | 0.0005 | 0.0002 | 0.0008 | 0.0001 | 0 | 0.0003 | 0 | 0.0001 | 0.0003 | 0 | 0 | 0.0001 | 0.0003 | 0 |
| Cytoplasm | 0.0337 | 0.0148 | 0.0033 | 0.027 | 0.0027 | 0.0063 | 0.0141 | 0.0067 | 0.0063 | 0.0131 | 0.0007 | 0.0095 | 0.0278 | 0.0015 | 0.0078 | 0.0054 | 0.0105 | 0.0028 |
| Cytoplasmic Foci | 0.0132 | 0.0031 | 0.001 | 0.0079 | 0.0005 | 0.0002 | 0.0072 | 0.0039 | 0.0055 | 0.0006 | 0.022 | 0.0002 | 0.0122 | 0 | 0.0079 | 0.0223 | 0.0087 | 0.0016 |
| Eisosomes | 0.0002 | 0 | 0 | 0.0001 | 0.0001 | 0 | 0.0003 | 0 | 0 | 0.0001 | 0 | 0 | 0.0005 | 0 | 0 | 0 | 0.0002 | 0 |
| Endoplasmic Reticulum | 0.0104 | 0.001 | 0.0018 | 0.0017 | 0.0069 | 0.0008 | 0.0056 | 0.0002 | 0.0004 | 0.0028 | 0.0001 | 0.001 | 0.0056 | 0.0017 | 0.0008 | 0.0008 | 0.0018 | 0.0011 |
| Endosome | 0.0225 | 0.004 | 0.0022 | 0.0166 | 0.0151 | 0.0036 | 0.025 | 0.0012 | 0.0037 | 0.0123 | 0.0225 | 0.0007 | 0.0295 | 0.0001 | 0.0121 | 0.0337 | 0.0057 | 0.0083 |
| Golgi | 0.0083 | 0.0031 | 0.0017 | 0.0222 | 0.0018 | 0.0001 | 0.0079 | 0.0035 | 0.0012 | 0.0015 | 0.022 | 0 | 0.0069 | 0 | 0.0038 | 0.0218 | 0.002 | 0.0015 |
| Lipid Particles | 0.011 | 0.0006 | 0.0002 | 0.0287 | 0.0026 | 0.0003 | 0.0158 | 0.0005 | 0.0012 | 0.0013 | 0.0072 | 0 | 0.0139 | 0 | 0.0015 | 0.0275 | 0.0023 | 0.0008 |
| Mitochondria | 0.0068 | 0.0013 | 0.0026 | 0.0107 | 0.0316 | 0.0172 | 0.0147 | 0.0006 | 0.0005 | 0.0169 | 0.0042 | 0.0003 | 0.0087 | 0.0001 | 0.0011 | 0.015 | 0.043 | 0.0067 |
| None | 0.0081 | 0.0006 | 0.0003 | 0.0004 | 0.0006 | 0.0003 | 0.0017 | 0.0001 | 0.0012 | 0.0013 | 0.0001 | 0.0004 | 0.013 | 0 | 0.0086 | 0.0003 | 0.0043 | 0.0006 |
| Nuclear Periphery | 0.0245 | 0.0181 | 0.027 | 0.0484 | 0.0723 | 0.0166 | 0.0312 | 0.0117 | 0.0068 | 0.0188 | 0.0017 | 0.0077 | 0.0225 | 0.0115 | 0.0132 | 0.0169 | 0.0122 | 0.0102 |
| Nucleolus | 0.0023 | 0.0032 | 0.0024 | 0.0023 | 0.0047 | 0.0057 | 0.0034 | 0.0018 | 0.0017 | 0.0034 | 0.0024 | 0.0045 | 0.0031 | 0.0024 | 0.0024 | 0.0012 | 0.0057 | 0.0047 |
| Nucleus | 0.7778 | 0.9423 | 0.9366 | 0.8118 | 0.8337 | 0.9359 | 0.7718 | 0.9376 | 0.9647 | 0.909 | 0.894 | 0.9648 | 0.803 | 0.9661 | 0.9173 | 0.8399 | 0.8323 | 0.9516 |
| Peroxisomes | 0.019 | 0.0003 | 0.0029 | 0.0118 | 0.0002 | 0.0001 | 0.0049 | 0.008 | 0.0022 | 0.0003 | 0.0209 | 0 | 0.0049 | 0 | 0.0033 | 0.0029 | 0.0101 | 0.0005 |
| Punctate Nuclear | 0.0222 | 0.004 | 0.0034 | 0.0018 | 0.0018 | 0.0038 | 0.0203 | 0.004 | 0.0019 | 0.0028 | 0.001 | 0.007 | 0.0113 | 0.0006 | 0.0043 | 0.0028 | 0.0379 | 0.0043 |
| Vacuole | 0.004 | 0.0009 | 0.0011 | 0.0022 | 0.01 | 0.0023 | 0.0139 | 0.0008 | 0.0002 | 0.0052 | 0.0002 | 0.0008 | 0.0038 | 0.0004 | 0.0018 | 0.0022 | 0.0024 | 0.0009 |
| Vacuole Periphery | 0.0017 | 0.0003 | 0.0021 | 0.0009 | 0.0099 | 0.0015 | 0.004 | 0.0001 | 0.0001 | 0.0029 | 0.0002 | 0.0002 | 0.0011 | 0.0001 | 0.0004 | 0.001 | 0.0028 | 0.0004 |
Sequencing Data
| R1 | R2 | |||||||||
|---|---|---|---|---|---|---|---|---|---|---|
| G1 Post-START | S/G2 | Metaphase | Anaphase | Telophase | G1 Post-START | S/G2 | Metaphase | Anaphase | Telophase | |
| Gene Expression | 41.5228 | 30.9617 | 44.3834 | 63.0377 | 32.4037 | 44.8434 | 51.2269 | 63.387 | 61.0364 | 48.9639 |
| Translational Efficiency | 0.7578 | 0.7827 | 0.797 | 0.5627 | 0.6678 | 0.8669 | 0.6607 | 0.5516 | 0.678 | 0.6425 |
Hit Data
| Dataset | Hit |
|---|---|
| Protein Concentration | ✘ |
| Protein Localization | ✘ |
| Gene Expression | ✘ |
| Translational Efficiency | ✘ |
Endocytosis
| Temp | Actin Patch (Sac6-tdTomato) | Cortical Patch (Sla1-GFP) | Late Endosome (Snf7-GFP) | Vacuole (Vph1-GFP) |
|---|---|---|---|---|
| 37℃ | ||||
| RT |
Cell Cycle Omics
CYCLoPs (Ecm29-GFP)
| Gene / Allele | Actin Patch (Sac6-tdTomato) | Cortical Patch (Sla1-GFP) | Late Endosome (Snf7-GFP) | Vacuole (Sac6-tdTomato) |
|---|
| Gene | Images |
|---|
| Gene | Images |
|---|
Images are not yet available
Images are not yet available